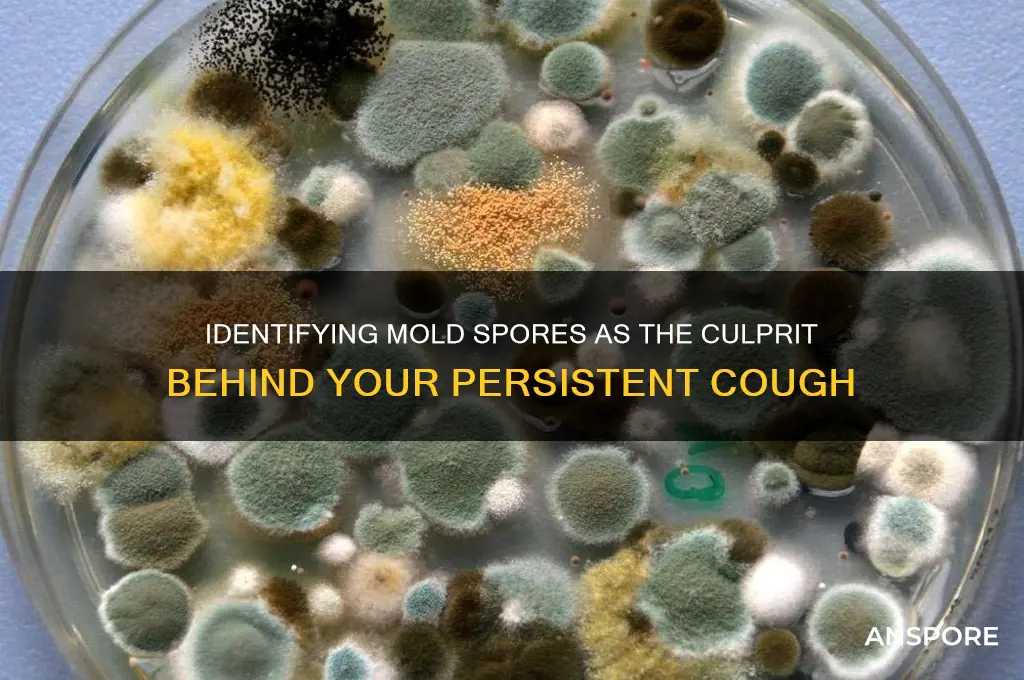
how to find out if mold spores cause my cough

If you suspect that mold spores might be causing your cough, it’s essential to investigate the presence of mold in your environment and assess your symptoms. Start by inspecting your home for visible mold growth, especially in damp areas like bathrooms, basements, or kitchens. Musty odors or water damage are also indicators of potential mold. Consider using a mold test kit or hiring a professional to confirm its presence. Additionally, monitor your symptoms—if your cough worsens indoors and improves when you’re away from home, mold could be a likely culprit. Consulting a healthcare provider for allergy testing or a respiratory evaluation can help determine if mold spores are triggering your cough. Addressing the source of mold and improving indoor air quality are crucial steps in alleviating symptoms.
| Characteristics | Values |
|---|---|
| Symptoms Indicative of Mold Exposure | Persistent cough, sneezing, runny/stuffy nose, itchy eyes, throat irritation, wheezing, skin rash, headaches, fatigue. |
| Environmental Clues | Visible mold growth, musty odor, water damage, high humidity (>60%), recent flooding, leaky pipes. |
| Diagnostic Tests | Allergy testing (skin prick or blood tests for mold-specific IgE antibodies), mold spore count in air samples, ERMI (Environmental Relative Moldiness Index) testing. |
| Medical Evaluation | Consultation with an allergist or pulmonologist for symptom assessment and medical history review. |
| Home Testing Kits | DIY mold test kits for air or surface samples (e.g., petri dishes, spore traps), though professional testing is more accurate. |
| Risk Factors | Living in damp/humid environments, history of allergies, asthma, or weakened immune system. |
| Prevention Measures | Fix leaks, reduce humidity with dehumidifiers, improve ventilation, clean moldy surfaces with appropriate solutions. |
| Treatment Options | Antihistamines, decongestants, nasal corticosteroids, immunotherapy (allergy shots), removing mold source. |
| Professional Inspection | Hiring certified mold inspectors to assess indoor air quality and identify hidden mold. |
| Time Frame for Symptoms | Symptoms may appear immediately or develop over time with prolonged exposure. |
Explore related products
What You'll Learn

Symptoms of mold exposure
Mold exposure can manifest in a variety of symptoms, often mimicking common ailments, which makes identifying the root cause challenging. One of the most frequent indicators is a persistent cough, especially if it worsens in specific environments, such as at home or in damp buildings. This cough may be accompanied by a sore throat, nasal congestion, or a runny nose, resembling allergy symptoms. If you notice these signs and they improve when you’re away from your home or workplace, mold spores could be the culprit. Monitoring the timing and location of your symptoms is a critical first step in determining whether mold is the cause.
Analyzing the broader spectrum of symptoms can provide further clarity. Mold exposure often triggers respiratory issues, including wheezing, difficulty breathing, and chest tightness, particularly in individuals with asthma. Skin reactions, such as rashes, itching, or dermatitis, may also occur, especially after direct contact with moldy surfaces. For children and the elderly, or those with compromised immune systems, symptoms can be more severe, including fatigue, headaches, and even fever. If multiple household members or coworkers experience similar symptoms, it strengthens the case for mold as the common denominator.
To investigate further, consider the environment where symptoms occur. Mold thrives in damp, humid areas, such as basements, bathrooms, or spaces with water damage. Visible mold growth, a musty odor, or recent flooding are red flags. Using a mold test kit or hiring a professional inspector can confirm its presence. If mold is detected, compare its location to where you spend the most time; proximity to moldy areas increases the likelihood of spore inhalation. Keep a symptom journal to track patterns and share this data with a healthcare provider for a more accurate diagnosis.
Practical steps can help mitigate symptoms while addressing the source. Improving ventilation by using dehumidifiers, fixing leaks, and cleaning moldy surfaces with a solution of one cup of bleach per gallon of water can reduce spore counts. For persistent coughs, over-the-counter antihistamines or nasal corticosteroids may provide relief, but these are temporary fixes. Long-term solutions require mold remediation. If symptoms are severe or persistent, consult a doctor, who may recommend allergy testing or a pulmonologist to assess respiratory health. Early intervention is key to preventing chronic health issues linked to prolonged mold exposure.
Mastering Spore: Copying Planets Made Easy in Simple Steps
You may want to see also

Testing for mold in your home
Mold spores are a common culprit behind persistent coughs, especially in individuals with allergies, asthma, or compromised immune systems. If you suspect mold in your home, testing can provide clarity. Professional mold inspectors use tools like moisture meters and air sampling pumps to detect hidden mold and measure spore levels. However, DIY mold test kits, available at hardware stores, offer a cost-effective alternative. These kits typically include swabs or air sampling cassettes that you send to a lab for analysis. While not as comprehensive as professional testing, they can identify the presence of mold and sometimes its type, helping you determine if mold spores are contributing to your cough.
Analyzing the results of a mold test requires understanding spore count thresholds. Indoor mold spore counts should ideally be lower than outdoor counts. If your test reveals elevated levels of mold spores indoors, particularly of allergenic species like *Cladosporium* or *Aspergillus*, it’s a strong indicator that mold could be triggering your cough. Cross-referencing these results with your symptoms—such as coughing worsening at home but improving outdoors—can strengthen the connection. Keep in mind that mold spores are microscopic and can circulate through HVAC systems, so localized testing in areas like basements, bathrooms, or near water leaks is crucial.
Testing for mold isn’t just about identifying its presence; it’s about pinpointing the source to address the root cause. For instance, mold often thrives in damp, poorly ventilated areas like crawl spaces, behind walls, or under sinks. If your test confirms mold, inspect these areas for signs of moisture intrusion, such as water stains, musty odors, or peeling paint. Addressing the moisture problem—whether it’s fixing a leaky pipe, improving ventilation, or using a dehumidifier—is essential to prevent mold recurrence. Without eliminating the source, mold will continue to release spores, potentially exacerbating your cough and other health issues.
While testing is a critical step, it’s equally important to interpret results with caution. False negatives can occur if mold is hidden or if the test area wasn’t representative. Conversely, detecting mold doesn’t always mean it’s the cause of your cough, as other factors like dust mites or pet dander could be at play. Consulting with a healthcare provider to rule out other causes and discussing your mold test results can provide a more complete picture. If mold is indeed the culprit, remediation by professionals may be necessary to ensure thorough removal and prevent further exposure, ultimately alleviating your symptoms.
Can Spore Syringes Contaminate During Storage Between Uses?
You may want to see also

Common mold-related respiratory issues
Mold spores are a common but often overlooked culprit behind persistent respiratory issues, including chronic coughs. These microscopic particles thrive in damp environments and can infiltrate your home without noticeable signs of mold growth. When inhaled, they irritate the airways, triggering a range of symptoms that mimic allergies or colds. Understanding the connection between mold exposure and respiratory problems is the first step in identifying whether your cough is mold-related.
One of the most telling signs of mold-induced respiratory issues is the pattern of your symptoms. If your cough worsens in specific locations, such as a damp basement or a room with poor ventilation, mold could be the cause. Other symptoms like wheezing, nasal congestion, and throat irritation often accompany mold exposure. For individuals with asthma, mold spores can exacerbate flare-ups, making it harder to breathe. Children, the elderly, and those with compromised immune systems are particularly vulnerable, as their bodies may struggle to defend against mold-related irritants.
To determine if mold is causing your cough, start by inspecting your living environment. Look for visible mold growth, musty odors, or signs of water damage. Common hiding spots include behind walls, under sinks, and in HVAC systems. If you suspect mold but can’t see it, consider using a mold test kit or hiring a professional inspector. These tests measure spore levels in the air, providing concrete evidence of mold presence. Keep in mind that even if mold is detected, not all types produce harmful spores, but it’s better to err on the side of caution.
Once mold is confirmed, addressing the source is crucial. Fix leaks, improve ventilation, and use dehumidifiers to reduce moisture levels below 50%. For small areas of mold (less than 10 square feet), you can clean it yourself using a solution of bleach and water. However, larger infestations require professional remediation to prevent spores from spreading. During cleanup, wear protective gear, including gloves, goggles, and an N95 mask, to avoid inhaling spores.
Preventing future mold growth is just as important as removing existing mold. Regularly clean areas prone to moisture, such as bathrooms and kitchens, and ensure proper airflow throughout your home. Monitor humidity levels and address any water intrusion promptly. If your cough persists despite these measures, consult a healthcare provider. They may recommend allergy testing or prescribe medications to manage symptoms. By taking a proactive approach, you can protect your respiratory health and create a mold-free living space.
Does Heat Effectively Eliminate Mold Spores on Food? Find Out Here
You may want to see also
Explore related products

Medical tests to diagnose mold allergies
A persistent cough can be a puzzling symptom, especially when it lingers without an apparent cause. If you suspect mold spores might be the culprit, medical tests can provide clarity. These tests are designed to identify whether your immune system is reacting to mold allergens, offering a scientific basis for your symptoms. Here’s how they work and what to expect.
Skin Prick Tests: A Quick Allergy Snapshot
One of the most common methods to diagnose mold allergies is the skin prick test. During this procedure, a small amount of mold allergen extract is applied to your skin, typically on the forearm or back, and then the skin is gently pricked. If you’re allergic, a raised, red bump (wheal) will appear within 15–20 minutes. This test is fast, minimally invasive, and suitable for adults and children over 2 years old. However, it’s not foolproof—false positives or negatives can occur, especially if you’re taking antihistamines, which should be avoided for 3–7 days before testing.
Blood Tests: Measuring IgE Antibodies
For those who can’t undergo skin testing, a blood test (specific IgE antibody test) is an alternative. This test measures the level of immunoglobulin E (IgE) antibodies in your blood, which your body produces in response to allergens like mold. A small blood sample is taken, usually from a vein in your arm, and sent to a lab for analysis. Results typically take a few days. While this method is less immediate than skin testing, it’s useful for people with skin conditions or those on medications that interfere with skin prick tests. Normal IgE levels vary by age, but elevated levels specific to mold allergens indicate a likely allergy.
Mold Exposure Assessment: Connecting the Dots
Diagnosing mold allergies isn’t just about testing your body’s reaction—it’s also about confirming mold exposure. If your home or workplace has visible mold, high humidity, or a musty odor, these are red flags. Professionals can conduct air quality tests to measure mold spore levels, often using spore traps or culture plates. While these tests don’t directly diagnose allergies, they provide critical context for your symptoms. For example, if your IgE test is positive and your home has elevated mold levels, the connection becomes clearer.
Elimination and Provocation: Practical Steps
Sometimes, the most telling test is observational. If you suspect mold is causing your cough, try a temporary elimination strategy. Spend a few days in a mold-free environment, such as a hotel or a friend’s home, and monitor your symptoms. If your cough improves, it’s a strong indicator. Conversely, a provocation test, where you’re exposed to mold under medical supervision, can confirm sensitivity. This is rarely done due to risks but can be definitive in ambiguous cases.
Understanding whether mold spores are causing your cough requires a combination of medical testing and environmental assessment. From skin prick tests to blood analysis and exposure evaluations, these tools work together to provide a comprehensive diagnosis. If you’re experiencing persistent symptoms, consult an allergist to determine the best course of action tailored to your situation.
Does Salmonella Form Spores? Unraveling the Truth About Its Survival
You may want to see also

Preventing mold growth indoors
Mold thrives in damp, humid environments, making moisture control the cornerstone of prevention. Aim to keep indoor humidity levels below 60%, ideally between 30% and 50%. Invest in a hygrometer to monitor humidity accurately. Dehumidifiers are invaluable in basements, bathrooms, and other prone areas, especially in climates with high ambient humidity. Ensure proper ventilation by using exhaust fans during showers, cooking, and laundry, and consider opening windows when weather permits.
Beyond humidity, mold requires organic material to grow, so deprive it of food sources. Regularly clean and dry surfaces prone to moisture, such as shower walls, kitchen counters, and under sinks. Fix leaks promptly—even small drips can create conditions for mold within 24–48 hours. Use mold-resistant products like paints and drywall in areas prone to dampness, such as bathrooms and basements. For existing mold, clean small areas (less than 10 square feet) with a solution of 1 cup bleach per gallon of water, wearing gloves and a mask to avoid spore inhalation.
Air circulation plays a critical role in mold prevention. Rearrange furniture to ensure air flows freely, especially around windows and exterior walls. In colder months, insulate pipes to prevent condensation, and ensure attics and crawl spaces are well-ventilated to avoid trapped moisture. For persistent issues, consider professional HVAC inspections to identify hidden mold in ducts or systems.
Finally, adopt proactive habits to deter mold. Wipe up spills immediately, dry wet clothing promptly, and avoid carpeting in basements or bathrooms. Store firewood and plants away from living areas, as they can harbor mold spores. For households with allergies or respiratory issues, HEPA air purifiers can reduce airborne spores. While these measures won’t eliminate all mold risks, they significantly lower the likelihood of growth, reducing the chance that spores become the culprit behind persistent coughs.
Milky Spore's Impact on Fireflies: Uncovering the Truth
You may want to see also
Frequently asked questions
Start by assessing your environment for visible mold, musty odors, or water damage. If symptoms like coughing worsen at home or in specific areas, consult a healthcare provider for allergy testing or a mold exposure assessment.
Mold-related coughs often accompany other symptoms like sneezing, nasal congestion, itchy eyes, throat irritation, or wheezing. Persistent or worsening symptoms in moldy environments suggest mold as a potential cause.
Use a mold test kit to collect air or surface samples, or hire a professional mold inspector. Combine test results with a medical evaluation to determine if mold spores are triggering your cough.

























